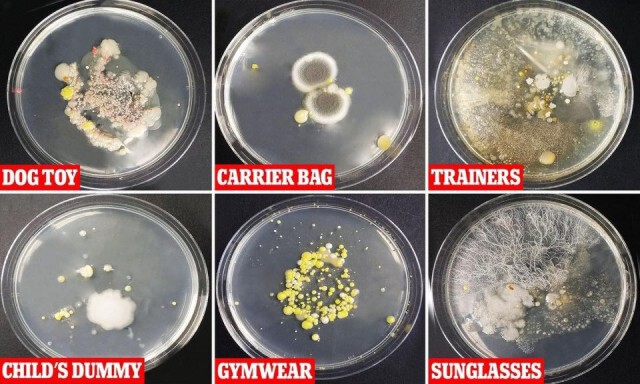
อึ้งเลย! งานวิจัยชี้พบเชื้อโรคในแว่นกันแดดมากกว่าบนโถส้วม

อึ้งเลย! งานวิจัยชี้พบเชื้อโรคในแว่นกันแดดมากกว่าบนโถส้วม
01 ก.ย. 2563

ทำเอาคนมีรถต้องอึ้งไปตามๆกัน เมื่องานวิจัยจากประเทศอังกฤษชี้ชัด "แว่นกันแดด" ที่วางทิ้งไว้ในรถ มีเชื้อโรคทั้งเชื้อราและแบคทีเรียมากกว่าโถส้วมในห้องน้ำเสียอีก
lifestyle1
01 ก.ย. 2563

ทำเอาคนมีรถต้องอึ้งไปตามๆกัน เมื่องานวิจัยจากประเทศอังกฤษชี้ชัด "แว่นกันแดด" ที่วางทิ้งไว้ในรถ มีเชื้อโรคทั้งเชื้อราและแบคทีเรียมากกว่าโถส้วมในห้องน้ำเสียอีก
ศูนย์วิจัยโรคปรสิต สำนักวิชาแพทยศาสตร์ มหาวิทยาลัยเทคโนโลยีสุรนารี โพสต์ข้อความผ่านเพจเฟซบุ๊ก ระบุถึงงานวิจัยจากประเทศอังกฤษที่ทำให้บรรดาคนมีรถต้องอึ้งไปตามๆกัน โดยมีข้อความดังนี้...
เชื้อแบคทีเรียและเชื้อราพบในแว่นกันแดดมากกว่าโถส้วมในห้องน้ำ รายงานวิจัยจาก London Metropolitan University ประเทศอังกฤษ
.
จากภาพจะเห็นจานเพาะเชื้อที่มีทั้งราและแบคทีเรียที่สามารถก่อโรคสู่คนได้ จากการที่นักวิจัยจากมหาวิทยาลัยดังข้าวต้นได้นำตัวอย่างที่ได้จากแว่นตา ของเด็กเล่น ของเล่นสุนัข ถุงใส่ของ เสื้อผ้าและรองเท้าใส่ออกกำลังกาย
เมื่อวางไว้ในรถที่อุณหภูมิสูง 33 องศาเซลเซียส ยิ่งหลายวันยิ่งทำให้เชื้อเจริญเติบโตได้ดี โดยเฉพาะแว่นตาที่มีทั้งราและแบคทีเรีย Staphylococcus epidermidis จำนวนมาก
เห็นอย่างนี้แล้ว ต้องหมั่นทำความสะอาดวัสดุอุปกรณ์เครื่องใช้เป็นประจำเพื่อป้องกันโรค และไม่ควรวางไว้ในรถด้วย


.

.
ข่าวล่าสุด